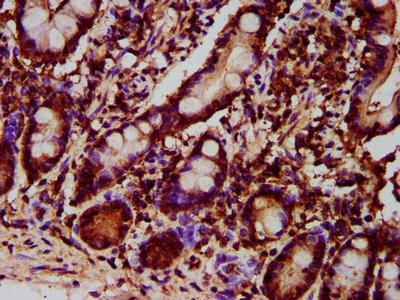

-
中文名稱:GPT2兔多克隆抗體
-
貨號:CSB-PA823460LA01HU
-
規格:¥440
-
圖片:
-
Western Blot
Positive WB detected in: U87 whole cell lysate
All lanes: GPT2 antibody at 4.5µg/ml
Secondary
Goat polyclonal to rabbit IgG at 1/50000 dilution
Predicted band size: 58, 47 kDa
Observed band size: 58 kDa -
IHC image of CSB-PA823460LA01HU diluted at 1:700 and staining in paraffin-embedded human small intestine tissue performed on a Leica BondTM system. After dewaxing and hydration, antigen retrieval was mediated by high pressure in a citrate buffer (pH 6.0). Section was blocked with 10% normal goat serum 30min at RT. Then primary antibody (1% BSA) was incubated at 4°C overnight. The primary is detected by a biotinylated secondary antibody and visualized using an HRP conjugated SP system.
-
-
其他:
產品詳情
-
產品名稱:Rabbit anti-Homo sapiens (Human) GPT2 Polyclonal antibody
-
Uniprot No.:
-
基因名:GPT2
-
別名:AAT2 antibody; Alanine aminotransferase 2 antibody; ALAT2_HUMAN antibody; ALT2 antibody; Glutamate pyruvate transaminase 2 antibody; Glutamic alanine transaminase 2 antibody; Glutamic pyruvate transaminase (alanine aminotransferase) 2 antibody; Glutamic pyruvic transaminase 2 antibody; Glutamic--alanine transaminase 2 antibody; Glutamic--pyruvic transaminase 2 antibody; GPT 2 antibody; gpt2 antibody
-
宿主:Rabbit
-
反應種屬:Human
-
免疫原:Recombinant Human Alanine aminotransferase 2 protein (95-208AA)
-
免疫原種屬:Homo sapiens (Human)
-
標記方式:Non-conjugated
本頁面中的產品,GPT2 Antibody (CSB-PA823460LA01HU),的標記方式是Non-conjugated。對于GPT2 Antibody,我們還提供其他標記。見下表:
-
克隆類型:Polyclonal
-
抗體亞型:IgG
-
純化方式:>95%, Protein G purified
-
濃度:It differs from different batches. Please contact us to confirm it.
-
保存緩沖液:Preservative: 0.03% Proclin 300
Constituents: 50% Glycerol, 0.01M PBS, pH 7.4 -
產品提供形式:Liquid
-
應用范圍:ELISA, WB, IHC
-
推薦稀釋比:
Application Recommended Dilution WB 1:500-1:5000 IHC 1:500-1:1000 -
Protocols:
-
儲存條件:Upon receipt, store at -20°C or -80°C. Avoid repeated freeze.
-
貨期:Basically, we can dispatch the products out in 1-3 working days after receiving your orders. Delivery time maybe differs from different purchasing way or location, please kindly consult your local distributors for specific delivery time.
-
用途:For Research Use Only. Not for use in diagnostic or therapeutic procedures.
相關產品
靶點詳情
-
功能:Catalyzes the reversible transamination between alanine and 2-oxoglutarate to form pyruvate and glutamate.
-
基因功能參考文獻:
- The GPT2 gene demonstrates increasing expression in brain in the early postnatal period, and GPT2 protein localizes to mitochondria. Akin to the human phenotype, Gpt2-null mice exhibit reduced brain growth. Through metabolomics and direct isotope tracing experiments, we find a number of metabolic abnormalities associated with loss of Gpt2 PMID: 27601654
- Recessively inherited loss of function GPT2 mutations are a novel cause of intellectual disability. PMID: 25758935
- ATF4 silencing prevented the activating effect of histidinol and tunicamycin on ATF4 and ALT2 expression. Our findings point to ALT2 as an enzyme involved in the metabolic adaptation of the cell to stress PMID: 24418603
- expression of GPT2 especially in muscle and fat, suggests a unique and previously unrecognized role of this gene product in glucose, amino acid, and fatty acid metabolism and homeostasis. PMID: 11863375
- The biliary IL-6 and TNF-alpha levels were positively correlated with serum DBIL, TBA and gamma-GT levels in infantile hepatitis syndrome subjects. PMID: 17109502
- Elevation of liver enzymes and hepatic insulin resistance as reflected by fasting insulin occur in the early stages of insulin resistance and highlight the central role of the liver in insulin resistance in the general population. PMID: 17596883
- A clinical method for selective measurement of ALT1 and 2 in human plasma is described. PMID: 19360321
顯示更多
收起更多
-
相關疾病:Mental retardation, autosomal recessive 49 (MRT49)
-
蛋白家族:Class-I pyridoxal-phosphate-dependent aminotransferase family, Alanine aminotransferase subfamily
-
組織特異性:Expressed at high levels in muscle, adipose tissue, kidney and brain and at lower levels in the liver and breast.
-
數據庫鏈接:
Most popular with customers
-
-
YWHAB Recombinant Monoclonal Antibody
Applications: ELISA, WB, IHC, IF, FC
Species Reactivity: Human, Mouse, Rat
-
Phospho-YAP1 (S127) Recombinant Monoclonal Antibody
Applications: ELISA, WB, IHC
Species Reactivity: Human
-
-
-
-
-